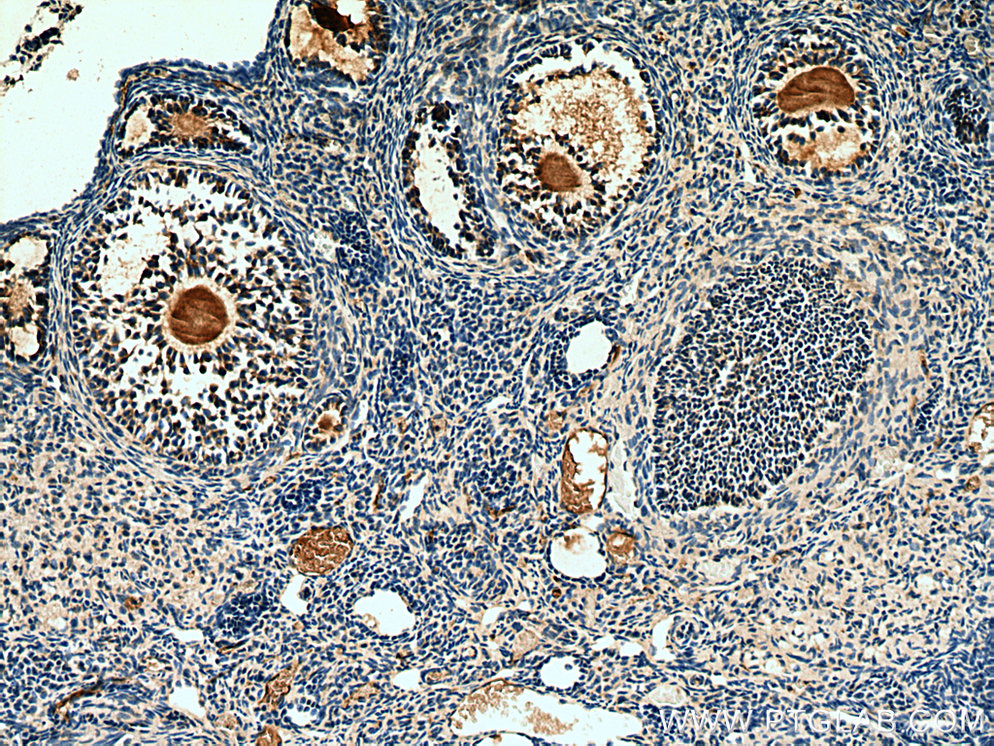

验证数据展示
经过测试的应用
| Positive WB detected in | human testis tissue |
| Positive IHC detected in | mouse ovary tissue, human pancreas tissue, rat ovary tissue, human ovary tumor tissue, human testis tissue Note: suggested antigen retrieval with TE buffer pH 9.0; (*) Alternatively, antigen retrieval may be performed with citrate buffer pH 6.0 |
| Positive IF-P detected in | mouse ovary tissue |
推荐稀释比
| 应用 | 推荐稀释比 |
|---|---|
| Western Blot (WB) | WB : 1:500-1:1000 |
| Immunohistochemistry (IHC) | IHC : 1:50-1:500 |
| Immunofluorescence (IF)-P | IF-P : 1:50-1:500 |
| It is recommended that this reagent should be titrated in each testing system to obtain optimal results. | |
| Sample-dependent, Check data in validation data gallery. | |
产品信息
14461-1-AP targets AMH in WB, IHC, IF-P, ELISA applications and shows reactivity with human, mouse, rat samples.
| 经测试应用 | WB, IHC, IF-P, ELISA Application Description |
| 文献引用应用 | WB, IHC, IF |
| 经测试反应性 | human, mouse, rat |
| 文献引用反应性 | human, mouse, rat, pig, chicken, sheep, goat |
| 免疫原 |
CatNo: Ag5670 Product name: Recombinant human AMH protein Source: e coli.-derived, PET28a Tag: 6*His Domain: 211-560 aa of BC049194 Sequence: GLALTLQPRGEDSRLSTARLQALLFGDDHRCFTRMTPALLLLPRSEPAPLPAHGQLDTVPFPPPRPSAELEESPPSADPFLETLTRLVRALRVPPARASAPRLALDPDALAGFPQGLVNLSDPAALERLLDGEEPLLLLLRPTAATTGDPAPLHDPTSAPWATALARRVAAELQAAAAELRSLPGLPPATAPLLARLLALCPGGPGGLGDPLRALLLLKALQGLRVEWRGRDPRGPGRAQRSAGATAADGPCALRELSVDLRAERSVLIPETYQANNCQGVCGWPQSDRNPRYGNHVVLLLKMQARGAALARPPCCVPTAYAGKLLISLSEERISAHHVPNMVATECGCR 种属同源性预测 |
| 宿主/亚型 | Rabbit / IgG |
| 抗体类别 | Polyclonal |
| 产品类型 | Antibody |
| 全称 | anti-Mullerian hormone |
| 别名 | Muellerian-inhibiting factor, Muellerian inhibiting factor, Anti-Muellerian hormone (AMH), Anti-Muellerian hormone, anti Mullerian hormone |
| 计算分子量 | 59 kDa |
| 观测分子量 | 60-65 kDa |
| GenBank蛋白编号 | BC049194 |
| 基因名称 | AMH |
| Gene ID (NCBI) | 268 |
| RRID | AB_10915986 |
| 偶联类型 | Unconjugated |
| 形式 | Liquid |
| 纯化方式 | Antigen affinity purification |
| UNIPROT ID | P03971 |
| 储存缓冲液 | PBS with 0.02% sodium azide and 50% glycerol, pH 7.3. |
| 储存条件 | Store at -20°C. Stable for one year after shipment. Aliquoting is unnecessary for -20oC storage. |
背景介绍
Anti-Müllerian hormone (AMH), also called Müllerian-inhibiting substance (MIS), is a hormone that is best known for its production by fetal testes in mammals and as the inhibitor of Müllerian duct development in males. AMH is also expressed in granulosa cells of preantral and small antral follicles in the ovary. More recently, AMH has been studied for its role in ovarian folliculogenesis and as a potential marker of ovarian reserve. The deduced protein sequence of the AMH monomer contains a 25 amino acid secretion specific signal peptide and a monomeric protein of 535 amino acids that, when glycosylated at two glycosylation sites, has a molecular weight of 65-70 kDa. This antibody is specific to AMH.
实验方案
| Product Specific Protocols | |
|---|---|
| IF protocol for AMH antibody 14461-1-AP | Download protocol |
| IHC protocol for AMH antibody 14461-1-AP | Download protocol |
| WB protocol for AMH antibody 14461-1-AP | Download protocol |
| Standard Protocols | |
|---|---|
| Click here to view our Standard Protocols |
发表文章
| Species | Application | Title |
|---|---|---|
Basic Clin Pharmacol Toxicol Effects of quercetin on ovarian function and regulation of the ovarian PI3K/Akt/FoxO3a signalling pathway and oxidative stress in a rat model of cyclophosphamide-induced premature ovarian failure | ||
Reprod Sci Menstrual Blood-Derived Endometrial Stem Cells Ameliorate Ovarian Senescence by Relieving Oxidative Stress-Induced Inflammation | ||
Theriogenology miR-140-3p promotes follicle granulosa cell proliferation and steroid hormone synthesis via targeting AMH in chickens
| ||
Comb Chem High Throughput Screen Regulation of Curcumin on Follicle Initiation Rate in Diminished Ovarian Reserve | ||
Tissue Cell HGF-modified human umbilical cord mesenchymal stem cells rescue impaired ovarian reserve function in chemotherapy-induced POI rats by improving angiogenesis while decreasing apoptosis and fibrosis in the ovary |